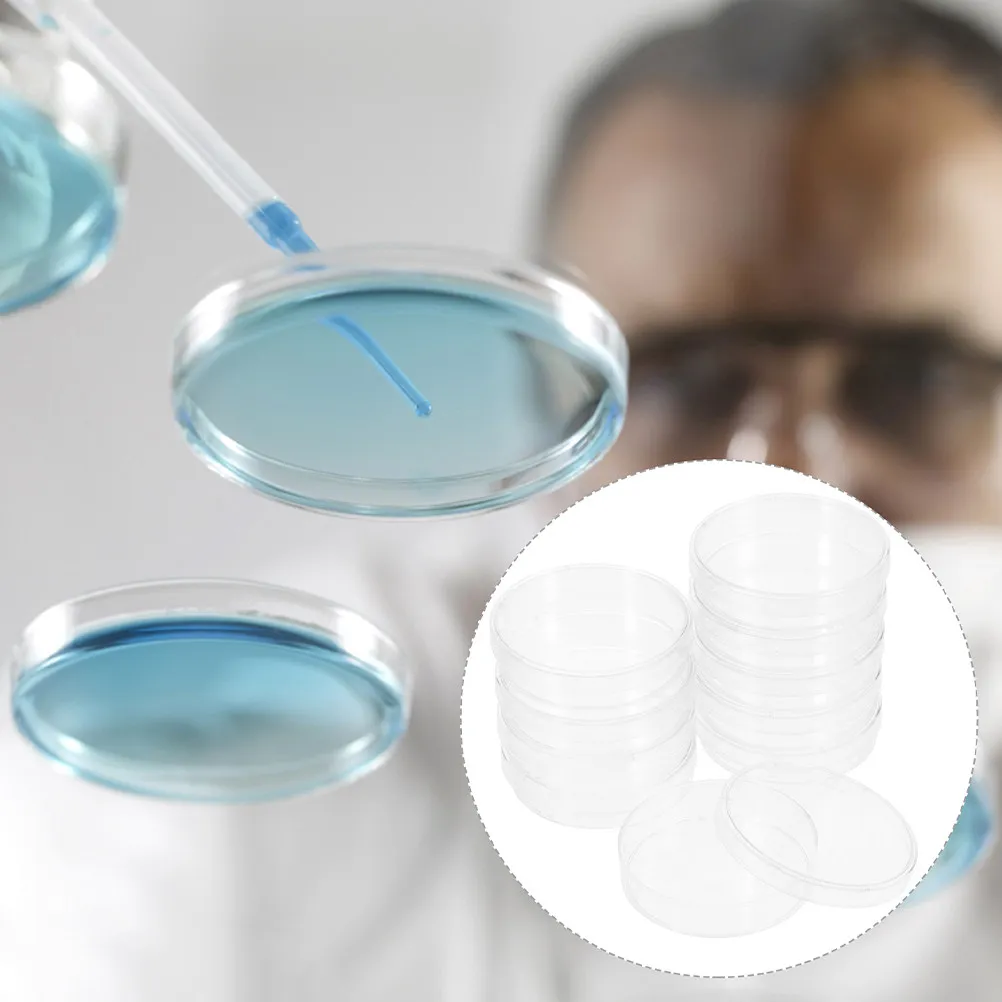
30Pcs Petri Dishes Plastic Small Clear Compact Lightweight for Laboratory Chemistry Research Science Supplies Culture Agar

Boost Board Module LCD TCON Board VGL VGH VCOM AVDD 4 Adjustable Gold-92E

sku: 4001112233303
ACCORDING TO OUR RECORDS THIS PRODUCT IS NOT AVAILABLE NOW
$3.95
Shipping from: China
Price history chart & currency exchange rate
Customers also viewed
/zhinochii-gamanets-calvin-klein-ck-must-lg-z-a-wallet-w-slip-emb-k60k611322-sheer-blue-cfx-8720108585972.jpg)
$54.75
Жіночий гаманець Calvin Klein Ck Must Lg Z/A Wallet W/Slip Emb K60K611322 Sheer Blue CFX, Голубий
modivo.ua
$20.64
Жіночі компресійні легінси. Штани для йоги. Безшовні штани з високою талією. Стрейч. Штани, що формують. Повсякденні спортивні штани для фітнесу. XL&XXL
joom.com
$14.02
External Automatic Toilet Flush Button Infrared Smart Toilet Flushing Sensor Elderly Battery type
joom.com
$2.81
Інструмент для втягування нитки в голку 3в1, Розтяжний засіб для видалення нитки, Багатофункціональний швейний помічник, Побутовий розпорювач швів, Втягування нитки, Портативний, Зручний One Size жовтий
joom.com![Snoopy Jinbei Top and Bottom Set Cotton Pajamas for Children Boys Girls 221157520 95 [Peanuts] 100% Off-White
Snoopy Jinbei Top and Bottom Set Cotton Pajamas for Children Boys Girls 221157520 95 [Peanuts] 100% Off-White](http://img.joomcdn.net/f902fce01a4330b952c5a22c37e1562c58019d39_original.jpeg)
$75.74
Snoopy Jinbei Top and Bottom Set Cotton Pajamas for Children Boys Girls 221157520 95 [Peanuts] 100% Off-White
joom.com
$11.48
Пасторальний набір ювелірних виробів Жіноча особистість Пшеничне колосся Намисто Кільце Ювелірні вироби Універсальні сережки
joom.com
$36.19
Женская блузка из белого шифона с длинным рукавом и бантом - Новый дизайн начала весны 2024 XL
joom.com
$7.03
Nepal Handmade Buddha Sound Bowl Cushion Random Color Singing Bowl Mat Stable Non-Slip High Grade Cotton Buddhist Ritual
aliexpress.com
$8.98
Wear-resistant 2026 Schedule Planner Thick Paper 365 Days Bookmark A5 Daily Planner Notebook Efficient Time Organizer
aliexpress.com
$6.85
30Pcs Petri Dishes Plastic Small Clear Compact Lightweight for Laboratory Chemistry Research Science Supplies Culture Agar
aliexpress.com
$7.38
20PCS PJ 63V68UF Volume 10X12.5MM Nichicon Electrolytic Capacitor UPJ1J680MPD6TD 68UF 63V NEW
aliexpress.com
$778.63
ASUS - ROG Ally 7" 120Hz FHD Gaming Handheld, AMD Ryzen Z1 Processor, 16GB RAM, 1TB SSD, AMD Radeon, Windows 11 Home, White
aliexpress.com
$2,994.57
Chinese Style Solid Wood Sofa Villa Homestay Hotel Straight Row Black Walnut Wood Leather Sofa
aliexpress.com
$104.92
4 Panel Wood Room Divider with Shelf, Foldable Privacy Screen for Bedroom Office Separation, 5.6 FT Wall Partition
aliexpress.com
$73.01
X9FA SAG55 Hot Air Blower 550W With Stand BGA Rework LCD Digital Hair Dryer Soldering
aliexpress.com
$1,682.84
ls 51North American black walnut rock slab coffee table living room household solid wood coffee table
aliexpress.com
$13.19
2026 Summer Fashion Striped Knit Polo Shirt Men Short Sleeve Turn-down Collar Knitted Tops Casual Mens Slim Fit Knitting Polos
aliexpress.com
$6.21
Multifunctional Fireplace Tape Seal Replace,Wooden Stoves Door Gasket Accessory for Chimney Glass Window Home Christmas Supplies
aliexpress.com
$0.65
10X Separation Friction Sheet Pad for Samsung JC73-00140A JC97-01931A JC67-00605A JC63-01669A ML1710
aliexpress.com
$22.17
DSMTRC Bohemian Style Multi Striped Shorts Cardigan Women Spring/Autumn Single Breasted Elegant Knitted Warm Full Sleeve Sweater
aliexpress.com
$9.20
Heated Rivalry T-shirt Stupid Canadian Wolf Bird T Shirt Top Funny Meme Men Women Fashion Clothes Graphic Tee Aesthetic Clothing
aliexpress.com
$16.74
New Chinese style sunscreen shirt jacket women's summer thin long-sleeved cardigan 2024 new
aliexpress.com
$1.36
Bicycle Bell Alloy for Safety Cycling Handlebar Ring Bicycle Call Bike Accessories Mountain Road Bike Horn Sound Alarm Bike Horn
aliexpress.com
$6.66
SANLIDA Archery X10 Stabilizer Quick Disconnect 0°/5°/10° CNC 6061 Aluminum Balanca Bar Compound Bow Accessories Target Archery
aliexpress.com
$7.38
Hat Scarf All-in-one Sanrio Anime Kuromi Children's Toy Cartoon Warm Ear Protection Velvet Melody Thickened Warm Hooded Scarf
aliexpress.com
$62.63
PaulFrank Retro Casual Pants Men's Spring Loose Drapey Versatile Knife Wide Leg Pants Youthful Trendy Straight Leg Trousers
aliexpress.com
$138.05
GURBAKS Men's Outdoor Work Pants Summer Thin American Retro Trend Loose Wide Leg Casual Pants Breathable Straight Tube Jeans
aliexpress.com
$26.78
Christmas Countdown Dice Calendar 2025 24 Days Christmas Countdown with Dice Set Seasonal Role Playing Table Game for Gamers
aliexpress.com
$89.95
New 4PP151.0571-01 Membrane Keypad For Power Panel 100 Repair,Available&Stock Inventory
aliexpress.com
$3.00
Cartoon Lamb Beanie Caps Thickened Coldproof Baby Ear Protection Hat Comfortable Windproof Children's Pullover Hats
aliexpress.com
$18.20
270° Piano Hinge 380/153mm x 26mm - Black Iron Continuous Hinge for Furniture & Jewelry Box, Includes Screws
aliexpress.com



